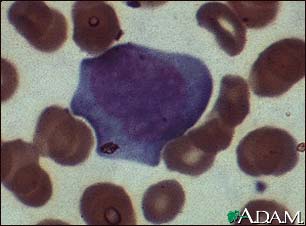
Mononucleosis, photomicrograph of cells Mononucleosis, photomicrograph of cells

![]() | ![]() | ![]() |
| | ||
Mononucleosis, photomicrograph of cells
This so-called "Downy cell" is typical of lymphocytes infected by EBV (Epstein Barr Virus) or CMV (Cytomegalovirus) in infectious mononucleosis. Downy cells may be classified as types I, II, or III. This is a type II Downy cell.
Update Date: 9/17/2008 Updated by: David C. Dugdale, III, MD, Professor of Medicine, Division of General Medicine, Department of Medicine. University of Washington School of Medicine; and Jatin M. Vyas, PhD, MD, Instructor in Medicine, Harvard Medical School, Assistant in Medicine, Division of Infectious Disease, Massachusetts General Hospital. Also reviewed by David Zieve, MD, MHA, Medical Director, A.D.A.M., Inc.
